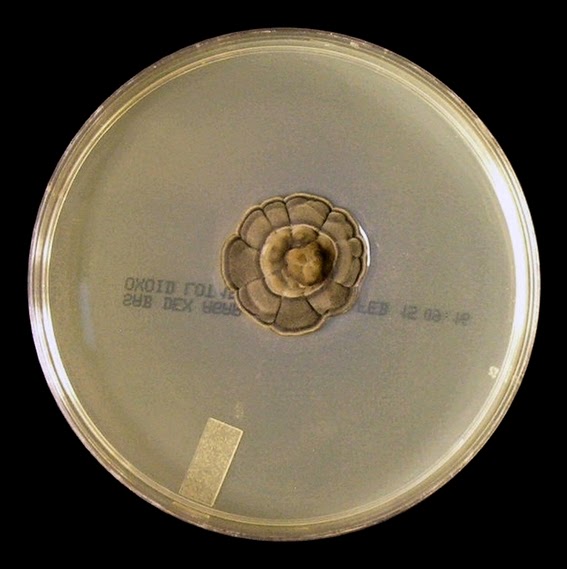
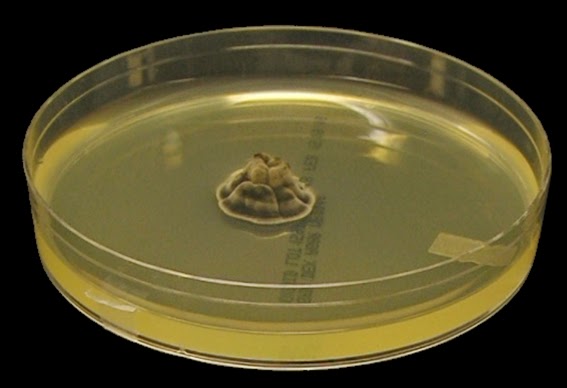
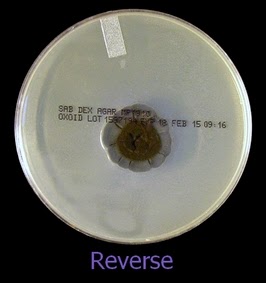

Exophiala jeanselmei-Mitosporic fungi; Hyphomycetes
Note: With the advent of molecular testing, some sources are stating that Exophiala jeanselmei should more correctly be referred to as the Exophiala jeanselmei complex. See explanation at the bottom of this post.
Also: Compare Exophiala jeanselmei with Exophiala dermatitidis elsewhere in this blog by clicking here.
Ecology:
Exophiala species can be found worldwide and may be isolated from soil, decaying wood and fresh water sources.
Pathogenicity:
Exophiala jeanselmei may be an agent of mycetoma[i]and phaeohyphomycosis[ii]has also been implicated as an agent of back grain mycetoma and chromoblastomycosis[iii]. While occurring worldwide, some evidence suggests that infections, particularly neurotropic infections, may be more prevalent in East Asia.
Macroscopic Morphology:
Colonies are initially moist and yeast-like in texture; however they soon form a velvety surface due to the production of aerial mycelia. Some isolated can remain yeast-like without further development.
The colony can be brownish-black to greenish-black with the reverse being black in colour.
Exophiala jeanselmei grows slowly, maturing within about 14 days at 25ᵒC to 30ᵒC.
Exophiala jeanselmei on SAB after incubation for 3 weeks at 30ᵒC.
While this isolate matured rather quickly, compared to the "up to 14 days" stated by some sources, the colony expanded outward slowly. (Nikon)
Exophiala jeanselmei on SAB after incubation for ~3 weeks at 30ᵒC.
Heaped up, folded appearance. (Nikon)
Young cultures with budding yeast-like cells may eventually develop septate hyphae. Hypha, initially hyaline (clear) become pale brown to olivaceous as the colony ages. The conidiogenous annellophores (structure producing annelloconidia) are slender, sometimes branched, and narrow towards the apex (tip). The smooth annelloconidia (2.5 – 6.0 µm X 1.2 – 2.5 µm) are oval or ellipsoidal in shape and if undisturbed, accumulate in clusters around the tip and upper sides of the annellide. Potato Dextrose Agar (PDA) or Corn Meal Agar (CMA) may enhance conidia production, however all the photos on this post were taken from isolates grown on Sabouraud Dextrose Agar (SAB) with copious conidia produced.
Exophiala jeanselmei - mycelial growth adhering to small piece of agar from a slide culture after 4 days of growth. (250X, LPCB, DMD-108)
Exophiala jeanselmei - small clusters or balls of conidia become evident, dispersed along the mycelia at this magnification. (250X, LPCB, Nikon)
Exophiala jeanselmei -Individual conida can now be made out at this magnification.
(400X, LPCB, DMD-108)
Exophiala jeanselmei -septate hyphae appear as if vacuolated. Conidiogenous structures (annellophores) do not appear to be highly differentiated from the hyphae themselves and can be intercalary (along the hyphae) or terminal (at the end of the hyphae).
(1000X, LPCB, DMD-108)
Exophiala jeanselmei -as above, with typical accumulation of the oval to ellipsoidal annelloconidia around the top, and along the sides of the annellophore.
(1000X, LPCB, DMD-108)
Exophiala jeanselmei -again, intercalary, and terminal production of annelloconidia.
(1000X, LPCB, DMD-108)
Exophiala jeanselmei -and another.
(1000+10X, LPCB, DMD-108)
Exophiala jeanselmei -Both clusters of conidia and individual conidia can be seen at the tips of the annellophores. (1000, LPCB, DMD-108)
Exophiala jeanselmei -Branched annellophore with (annello)conidia.
(1000+10X, LPCB, DMD-108)
Exophiala jeanselmei - and another...
(1000+10X, LPCB, DMD-108)
Exophiala jeanselmei - ditto, as above.
(1000+10X, LPCB, DMD-108)
Exophiala jeanselmei -branched conidiophore at various stages of conidia production.
(1000+10X, LPCB, DMD-108)
Exophiala jeanselmei -okay, too many photos of the same structures!!
(1000+10X, LPCB, DMD-108)
Exophiala jeanselmei -the annellophore appears undifferentiated from the hyphae from which it arises. Nice photo showing the annelloconidia accumulated around the apex of the annellophore from which they were produced. Conidia are single-celled with the darkly staining band across the center of the conidia not being a septum. Also visible on many of the conidia is the remnants of a fringe, the scar that remains from where they were attached to the conidiophore. This represents a specific method of reproduction and fringe or scar (annellide) is why we specify the conidiophore as an annellophore, and the conidia as an annelloconidia. (1000+10X, LPCB, DMD-108)
Exophiala jeanselmei -as the colony matures, the hypha become pigmented which gives the colony its distinctive colour. (1000X, LPCB, DMD-108)
Exophiala jeanselmei -as above, just another view,
(1000X, LPCB, DMD-108)
Exophiala jeanselmei -an interesting shot showing the annellophore rising upwards from it's parent hyphae with the annelloconidia clustered about the apex. Almost three-dimensional.
(1000X, LPCB, DMD-108)
Exophiala jeanselmei -copious amounts of conidia are produced.
(1000X, LPCB, DMD-108)
Exophiala jeanselmei -as previously stated, the darkly staining band across the center of the annelloconidium is not a septum. The single-celled annelloconidia have the fringe or scar which remains at one end of the cell which is why the conidia are specifically referred to as annelloconidia.
(1000+10X, LPCB, DMD-108)
Exophiala jeanselmei -conidium germinating.
(1000X, LPCB, DMD-108)
Exophiala jeanselmei -annelloconidia (1000+10X, LPCB, DMD-108)
[i] Mycetoma is a chronic, progressively destructive morbid inflammatory disease usually of the foot but any part of the body can be affected. Infection is most probably acquired by traumatic inoculation of certain fungi or bacteria into the subcutaneous tissue. (WHO)
[ii] Phaeohyphomycosis is a heterogeneous group of mycotic infection caused by dematiaceous fungi whose morphologic characteristics in tissue include hyphae, yeast-like cells, or a combination of these. (Wikipedia)
[iii] Chromoblastomycosis is a chronic fungal infection of the skin and the subcutaneous tissue caused by traumatic inoculation of a specific group of dematiaceous fungi. (Medscape)
Note: As with most fungi, speciation of the genus Exophiala is undergoing change brought about by molecular analysis. Some sources are now referring to the ‘Exophiala jeanselmei complex’.
Isolates from the United States that in the past had been identified as E. jeanselmei based on morphologic and physiologic characteristic have been shown by molecular methods to be mostly two newly named species closely related to E.jeanslemei, i.e. Exophiala oligosperma and Exophiala xenobiotica. A lower percentage were found to belong to several other species of Exophiala. The precise species in the complex can only be determined by molecular testing.
* * *